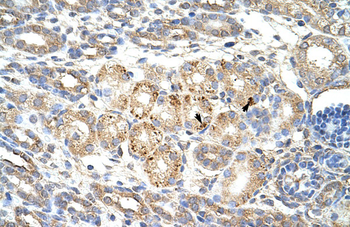
WNT9B Rabbit Polyclonal Antibody

You have no items in your shopping cart.
Cart summary
Item 1 of 2
Item 1 of 2
WNT9B Antibody
Catalog Number: orb1249530
Product Properties
| Catalog Number | orb1249530 |
|---|---|
| Category | Antibodies |
| Description | WNT9B Antibody |
| Target | WNT9B |
| Clonality | Polyclonal |
| Conjugation | Unconjugated |
| Reactivity | Human, Mouse |
| Predicted Reactivity | Rat |
| Form/Appearance | Liquid |
| Concentration | 500 ug/mL |
| Buffer/Preservatives | Supplied at 0.5 mg/ml in Tris saline, 0.02% sodium azide, pH 7.3 with 0.5% bovine serum albumin. Aliquot and store at -20°C. Minimize freezing and thawing. |
| Purification | Purified from goat serum by ammonium sulphate precipitation followed by antigen affinity chromatography using the immunizing peptide. |
| Immunogen | The immunogen for this antibody is: C-KRGNKDLRARADA |
| UniProt ID | O14905 |
| Tested applications | ELISA, WB |
| Application notes | Peptide ELISA: antibody detection limit dilution 1:8000.Western Blot:Approx 38kDa band observed in Human Brain Cerebellum lysates and in Mouse Kidney and Brain lysates (calculated MW of 39kDa according to NP_003387.1). Recommended concentration: 0.3-1ug/ml. |
| Antibody Type | Primary Antibody |
| Storage | Maintain refrigerated at 2-8°C for up to 2 weeks. For long term storage store at -20°C in small aliquots to prevent freeze-thaw cycles. |
| Alternative names | WNT9B, wingless-type MMTV integration site family, Read more... |
| Note | For research use only |
| NCBI | NP_003387.1 |
Images

orb1249530 (0.3 ug/ml) staining of Human Brain Cerebellum lysate (35 ug protein in RIPA buffer). Primary incubation was 1 hour. Detected by chemiluminescence.

orb1249530 (1 ug/ml) staining of Mouse Kidney (A) and Brain (B) lysate (35 ug protein in RIPA buffer). Primary incubation was 1 hour. Detected by chemiluminescence.
Similar Products
Human Wingless Type MMTV Integration Site Family, Member 9B (WNT9B) ELISA Kit [orb780737]
Human
0.16-10 ng/mL
0.058 ng/mL
48 T, 96 TWNT9B Rabbit Polyclonal Antibody [orb577969]
WB
Bovine, Canine, Equine, Guinea pig, Mouse, Rabbit, Rat
Human
Rabbit
Polyclonal
Unconjugated
100 μl
Reviews
WNT9B Antibody (orb1249530)
Based on 0 reviews
Participating in our Biorbyt product reviews program enables you to support fellow scientists by sharing your firsthand experience with our products.
Login to Submit a Review